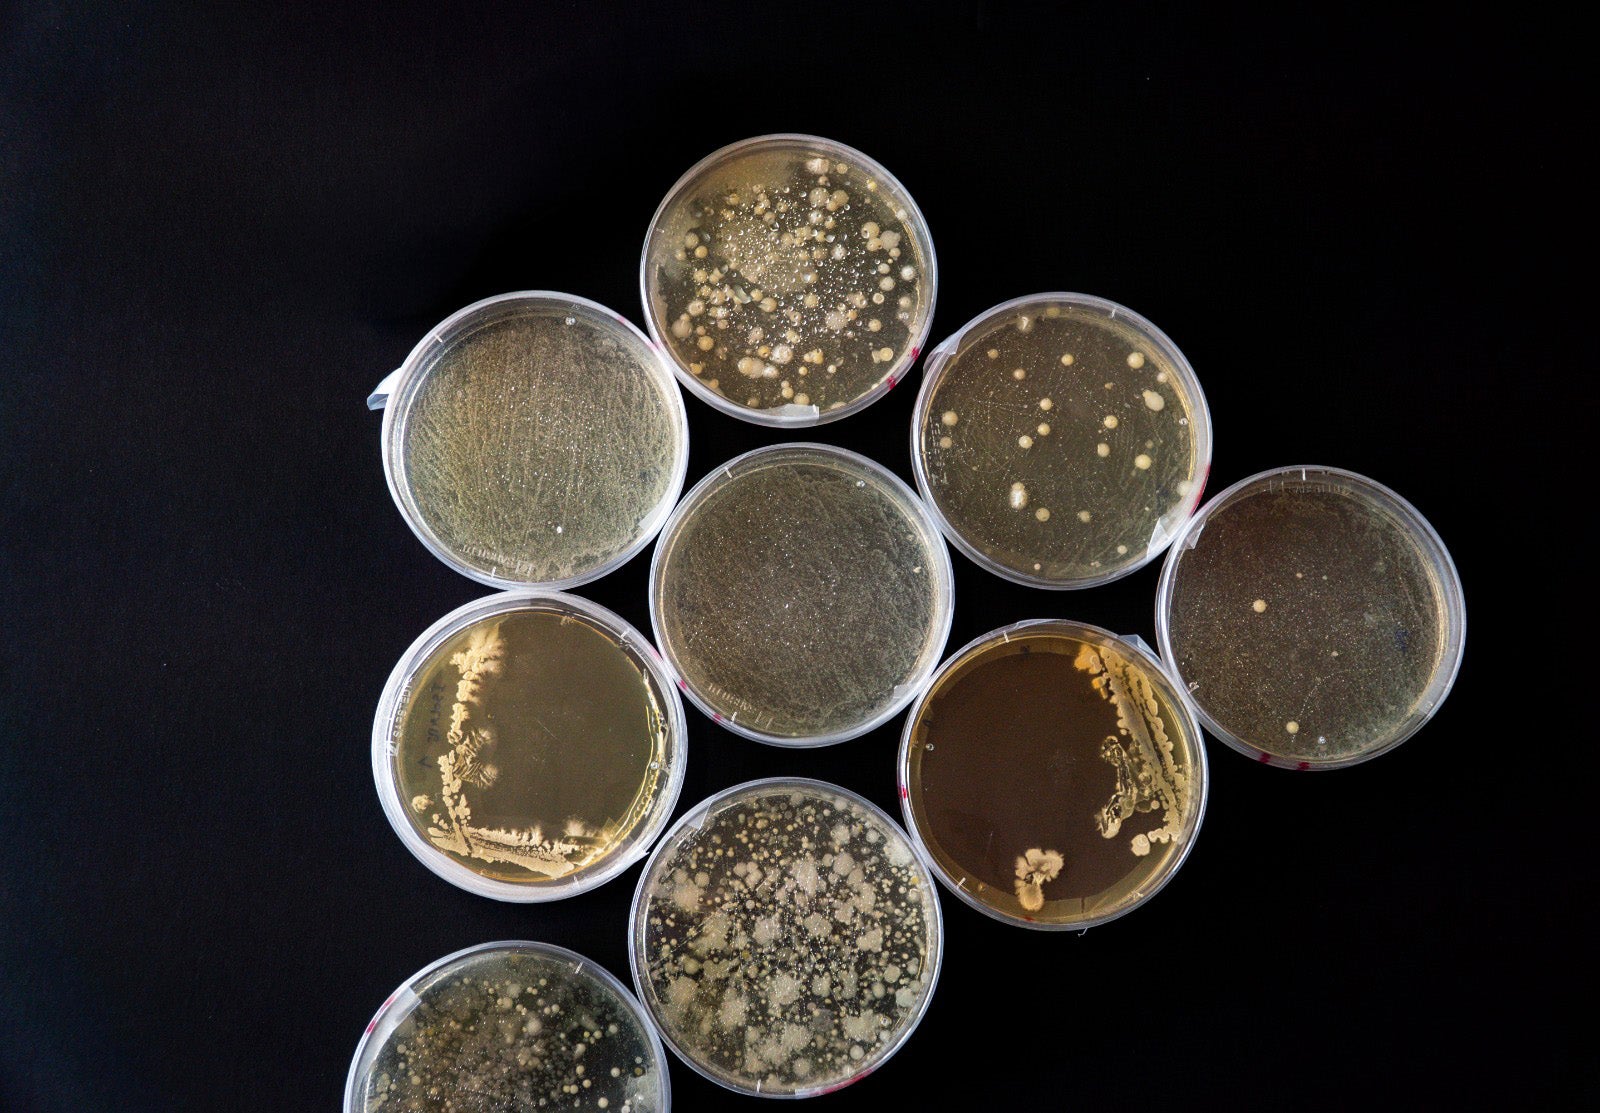

Mundo
Estudo da estrutura celular da tuberculose abre porta a novas estratégias de combate à doença
Uma equipa internacional de investigadores deu a conhecer um estudo que revela detalhes estruturais de uma 'peça' importante - o envelope celular - para a patogenicidade da bactéria que provoca a tuberculose. Este estudo, de acordo com os cientistas, pode contribuir para o desenvolvimento de estratégias que aumentem a eficácia de antibióticos já existentes ou até levar à criação de novas terapias com vista ao tratamento da segunda doença infeciosa mais mortal do mundo, a tuberculose.

Este agente patogénico mortal e único provoca todos os anos cerca de 1,3 milhões de mortes, sendo que mais de 10 milhões de pessoas padecem já da doença, apenas ultrapassada pela COVID-19 durante a recente pandemia.
Uma doença, que só por si já trazia desafios à ciência médica e que foi agravada pelo aparecimento de estirpes de Mycobacterium Tuberculosis, o agente causador da doença, resistentes a um ou mais antibióticos, o que torna urgente o desenvolvimento de novas terapias.
Mas o que torna esta bactéria tão resistente? Um dos principais fatores é a estrutura celular única - uma espécie de envelope biológico - que envolve a bactéria e que atua como um escudo contra vários antibióticos e defesas do nosso sistema imunitário. É por isso que o ‘envelope celular’ tem despertado tanto interesse entre os investigadores como alvo para o desenvolvimento de novas terapias contra a tuberculose.

Créditos: AFP / ilustração da bactéria da Tuberculose
Num estudo recente publicado na Nature Communications, uma equipa internacional, com investigadores do ITQB NOVA revelou a estrutura tridimensional da Arabinofuranosiltransferase (AftB), uma proteína envolvida na síntese de componentes que mantêm a integridade do envelope celular de M. tuberculosis.
Apesar da sua importância, até à data os mecanismos estruturais e funcionais da AftB eram pouco conhecidos.
Com recurso a criomicroscopia eletrónica (cryo-EM), uma técnica galardoada com o Prémio Nobel da Química em 2017, a equipa mapeou a estrutura desta proteína em detalhe, explica Margarida Archer, líder do laboratório de Cristalografia de Proteínas Membranares do ITQB NOVA e coautora do estudo.
“Descobrimos que a AftB tem uma cavidade distinta, irregular e em forma de tubo que permite a interação entre os dois substratos, moléculas de que necessita para desempenhar a sua função”.

Proteína AftB: Superfície da proteína AftB (verde) determinada por microscopia eletrónica. A imagem ilustra o seu centro ativo com um substrato ligado. Créditos: ITQB NOVA.
Inibir a síntese dos componentes do envelope celular já se revelou eficaz, por exemplo, com um medicamento de primeira linha contra a tuberculose, o etambutol.
"Embora sejam necessários mais estudos para explorar se a cavidade da AftB é um bom alvo terapêutico, esta caracterização da estrutura da proteína e das suas interações estabelece as bases para o desenvolvimento de novos fármacos”, avança José Rodrigues, investigador do ITQB NOVA e coautor do artigo.
Este trabalho insere-se num esforço contínuo de um consórcio internacional com a participação do ITQB NOVA e coordenado pelo Centro Médico da Universidade de Colômbia (EUA), que tem vindo a desvendar, de forma sistemática, a estrutura das arabinofuranosiltransferases em microbactérias.
Placas de Petri: Placas de Petri com microrganismos. Créditos: ITQB NOVA.
Desde 2020, o consórcio já publicou três estudos em revistas de referência, como a Nature Communications, Molecular Cell e Processes.
Dando continuidade a essa linha de investigação, os investigadores estão agora “a analisar mutações na AftB que possam estar relacionadas com a resistência a antibióticos, bem como a estudar enzimas relacionadas, como a AftA e a AftD, para compreender os seus mecanismos de ação”, explica Margarida Archer.
Paralelamente, a equipa está a recorrer a estratégias computacionais para identificar medicamentos já existentes no mercado que possam ser reaproveitados no combate à tuberculose.
